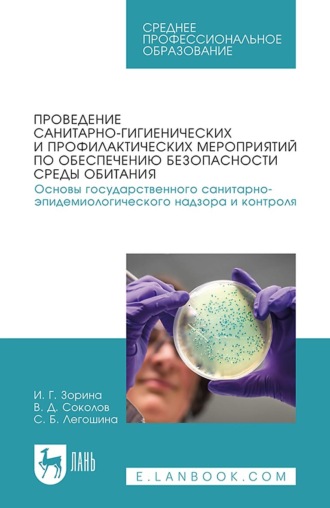
Проведение санитарно-гигиенических и профилактических мероприятий по обеспечению безопасности среды обитания. Основы государственного санитарно-эпидемиологического надзора и контроля. Учебное пособие для вузов

Проведение санитарно-гигиенических и профилактических мероприятий по обеспечению безопасности среды обитания. Основы государственного санитарно-эпидемиологического надзора и контроля. Учебное пособие для вузов
Автор:
Год написания книги: 2025
В пособии рассмотрены основы обеспечения санитарно-эпидемиологического благополучия и обеспечения населения и спасателей в условиях чрезвычайных ситуаций, методики оценки санитарно-эпидемиологического состояния в зонах катастроф, обследование эпидемиологических последствий в зоне чрезвычайных ситуаций.
Соответствует современным требованиям Федерального государственного образовательного стандарта среднего профессионального образования и профессиональным квалификационным требованиям.
На сайте электронной библиотеки Litportal вы можете скачать книгу Проведение санитарно-гигиенических и профилактических мероприятий по обеспечению безопасности среды обитания. Основы государственного санитарно-эпидемиологического надзора и контроля. Учебное пособие для вузов в формате fb2.zip, txt, txt.zip, rtf.zip, a4.pdf, a6.pdf, mobi.prc, epub, ios.epub, fb3. У нас можно прочитать отзывы и рецензии о этом произведении.